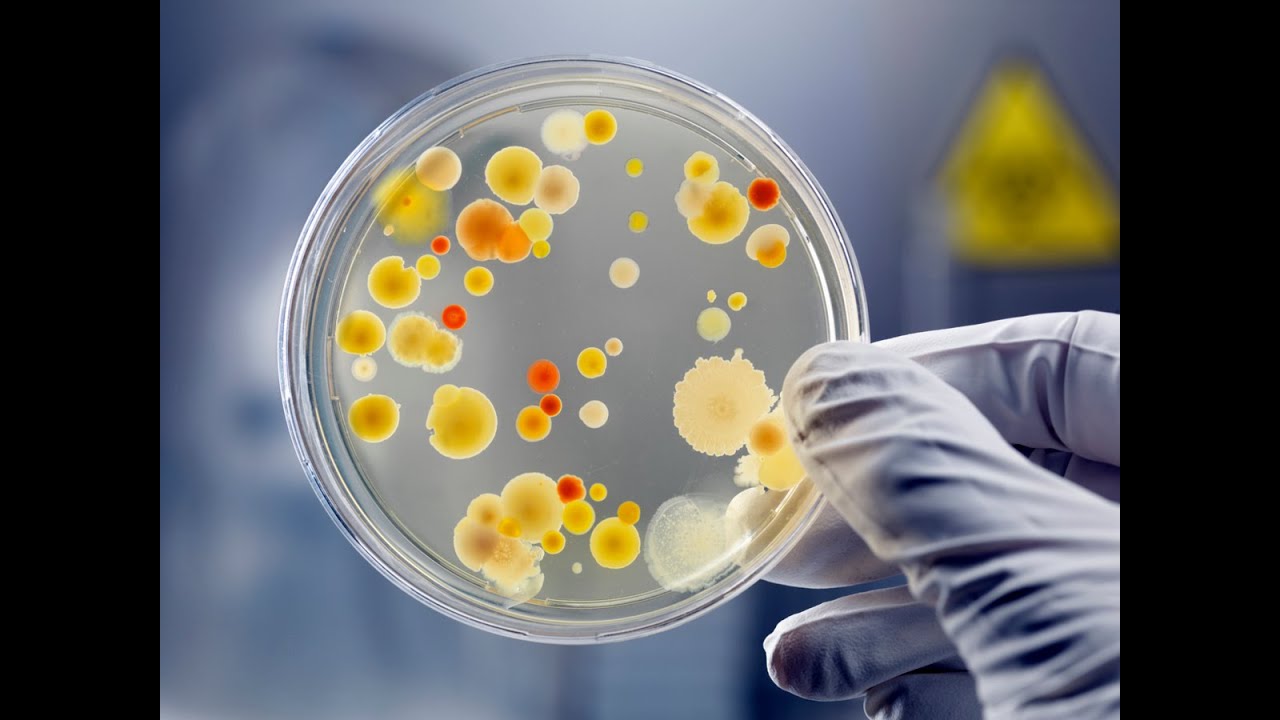
Preparo de diluições seriadas e Contagem de mesófilos aeróbios

eu sou marina docente do departamento de tecnologia e ciência de alimentos da universidade federal de santa maria e hoje apresentarei a técnica de número mais provável esta não é uma técnica de contagem e sim uma técnica de estimativa e ela tradicionalmente é utilizada para detecção de coliformes em alimentos também para detecção de vidro e a partir de alimentos ela ficando com diferentes etapas então tem uma etapa que é o teste que a gente chama presuntivo e outra que é o teste chamado conservatório pro teste presuntivo e a primeira trata nós utilizaremos um caldo lactosado o
sls ter lauril sulfato triptose e e depois nós vê se dá para seguintes para confirmação de que se trata realmente de coliformes nós utilizaremos os meios de verde brilhante desde que bi brilhante que possui em sua composição vi que é um inibidor de bactérias gram-positivas e principalmente gram-positivas e depois o caldo esse que é franja verificar a presença de coliformes termotolerantes mais especificamente esqueriquiacoli para realização dessa mostra então além dos meios de cultura estéril identificação causos nós trabalharemos com os múltiplos de 3 também pode ser 5 tubos múltiplos bom e depois será utilizada a o
crescimento do bastão do meio com produção de gás os ser utilizado um a tabela estatística para estimar a quantidade de dessas bactérias desses coliformes presentes em um alimento sei se vocês podem observar que no interior desse tubo tem um pouco menorzinho de vidro chamado de tubo de durhan esse tubo de durhan serve para reter o oxigênio produzido por esse grupo de bactérias se eles forem capazes de fermentar à lactose então é fermentação de lactose com produção de gás que será visualizado como uma bolha de ar dentro deste tubo de durham e às vezes o começo
fica pode ficar mais ou menos turvo silvestres bastão sem produção de gás esse em um tubo positivos o grupo dos coliformes é um grupo bastante relevante de bactérias e microbiologia alimentar visto que eles indica a presença de contaminantes de origem fecal existe um grande grupo que a gente considera os coliformes totais que são bactérias capazes de fermentar lactose a 37 graus conformação de graça e um homem dentro deste grande conjunto um grupo que chamamos de coliformes termotolerantes esses coliformes termotolerantes eles são capazes de fermentar lactose em 44 graus e meio com produção de gás e
desses coliformes maior parte desses coliformes termotolerantes tem origem no intestino e mais de noventa porcento deles são do gênio e gênio o fit accord então por isso que é a relevância visto gay a escherichia coli é um patógeno relevante para fran cardiologia de alimentos tendo importância como causador de doenças de transmissão alimentar além desses meios de cultura nós temos material básico para análises microbiológicas que é um saco espere o saco para homogenizador de amostra nós temos também 225/1 mililitros de água peptonada externo visto que nós trabalhamos com a nossa unidade analítica de 25 gramas trabalharemos
com uma mostra de salame e a granja linguiça colônia e também temos tubos contendo 9 litros de água que acostumada também está eles esperam para fazermos ajuda estão impetador automático ajustável entre um ms um litro que é o que nós precisaremos ponteiras externas algo para a gestão do ambiente de trabalho e o nosso bico de bolsa tá nós faremos a análise e rotineiro homogenização pesagem ou uma organização da mostra e depois será transferido as de diversões para os os tubos contendo lst esses tubos serão incubadas e os tubos que em 24 ou 48 horas até
48 horas apresentar a informação de gás e turvação do meio serão transferidos é para esses dois meses e incubadas nas temperaturas mais respectivas este para confirmação dos coliformes totais e este para confirmação da presença de coliformes termotolerantes e essa técnica dos tubos múltiplos ou número mais provável ela achou bastante espaço no lá e aí [Música] o formato dos rápidos principalmente em placas placas de métodos rápidos que sendo a mais conhecida a pepsico apresentar um esquema no quadro e depois a jéssica vai fazer realizar as análises e já salvaremos também da peppa e aqui nós temos
o esquema de uma várias vezes número mais provável que é uma análise que é frequentemente usada em microbiologia de alimentos para detecção de cor é realizada para a detecção de vida ela tem duas etapas uma realidade teste presuntivo e a outra é chamado de teste e confira o inicialmente a gente faz esse teste três antigo pega às vezes tem problema já mostra 225 milímetros de água perguntou nada um uma parte histórica para 9 líquidas de lição para dessa ou perna vamos um hoje isso se eu estou meio que durante um minuto ou então os mestres
drive y depois esperta hoje a realização então esse nosso homogenizado será a gestão moderna - 1 ou 0 1 não existe um litro de utilizada para um tubo contendo enorme litros de água peptonada ester e será a nossa direção merda menos dois e um milímetro aposto utilizado é transferido para um segundo turno contendo 9 milímetros de abertura nada e a nossa um dois três então já sabemos 13,00 um ou menos dois 7,01 e menos 10 vírgula uma ele é uma polêmica e depois que nós fizemos este material preparado nós transferimos para tubos contendo caldo lauril
sulfato triptose com tubinho de durham e se realmente esterilizado e servirá para tô de folga com presença executiva ele a cidade de tempo uniformes nesta mostra é pegaremos hifumi livro do terna menos três e transferimos para 3 tubos identificar entre as mesmas crenças contendo nesse meio rsc outra gelada de calcular seus é um pouco de dor como transferir apps tem um minuto para cada um dos setores da digestão menos dois e também um início para textos da direção menos um esses esse carro deve ter ele será encubados 37 graus de 24 a 48 horas é
aonde a leitura 24 horas em 20 é por causa de todos estarem positive porque caso for deles não consiste 24 e aí o que que tu não vai funcionar gap são um ponto positivo será ponto como uma bolha de ar dentro dele e possível informação no vídeo e se corridos às 20 das 24 horas três horas então vamos fazer a 48 horas nós vamos lá observar quis tubos positivos e darmos início ao teste confirmativo obviamente se não tiver nenhum teste positivo e 40 e essa não mas caixa laranja e aí a fazer aqui a cada
tu lcd positivo eu preciso de um título verde de caldo verde 20 diante correspondente e entender um de caldo ele teve correspondente identificaram com o mesmo número da tim e aí e aí é pegaremos com uma alça de inoculação para você de pertinho tem teremos uma função do calor sc e que transferimos para o cálculo ser diferente diante e cubanos a 17° formais 48 horas precisando e aí [Música] ah e também os mesmos mesmo aparecendo mesmo tudo que e eu cansei dei uma passada deixe para cabo usb no entanto nunca ou seja ele será em
cuba o graus c o serviço do que a partir desse meio de cultura nós nós queremos detectar os coliformes termotolerantes tv para cada doente ficar positivo de sp vai ter um tudo correspondente de vermelho brilhante e um tubo correspondente de cabo usb e com base nos quais são incubadas em temperaturas diferentes que será o térmico confira e depois de 8 horas nós vamos pegar o cinto pc e faremos a observar segundos em quantos desses estudos tiver e para mostrar para vocês um os tubos positivos e nós vamos contar quantos tubos tem essa formação de gás
essa volume de gás inscreva-se bom então a gente fazer o quê nós temos o esquema a atividade 31 para ver gigantes e 100 para o caldo e ter lembrado de mim o caldo ec 44.5 e nós nós pegamos o nosso resultado vamos supor os tubos estão mesmo sul produzir água é o número 13 dá menos 21 da mesma escrevi um obviamente que acredite duas três mas eu poderia ter feito mais de dois sonho e assim seria muito mais possibilidade só que como eu faço isso eu tenho que fazer o meu fator de nós não temos
essa a tabela existe uma tabela estatística no caso nós trabalhamos com três turnos ela pode ser feliz com cinco todos e essas três estamos nos não cacau desconfiando de noventa e cinco porcento nos resultados local de bebê o treco desses e não colado o hugo apenas um perdido estão me libertar menos um confirmou presença de termotolerância bom um tudo equivale a quantos micro-organismos é isso eu preciso terminar minha tabela então serve primeiro resultado de coliformes o telefone um procurando na tabela 13 1 equivale a 75 mm ps1 mínimo são dia o máximo do seu os
microorganismos presentes em cada grama dessa mostra micro-organismos então conexões totais e 100 procurando na nossa tabela ou 100 33,6 coliformes tolerantes por cada grama de amostra analisada no mínimo de 0,17 e o máximo de 18 coliformes termotolerantes para cada grama é analisada então eu é uma técnica relativamente simples de se executar e é muito importante ter cuidado na mão a confundir as eleições e prática para anotar adequadamente os números e consultar como cuidado a tabela nmp correspondente bom então aqui é o número um esquema que nós temos o número mais provável que é uma técnica
de bastante lembrança em microbiologia ali o olá eu sou a jéssica soletrando programa de pós-graduação de tecnologia de alimentos da universidade federal de santa maria e hoje farei a técnica dos sulcos múltiplos outros número mais provável também conhecido como mp antes de começar qualquer técnica numa bobagem cronologia deve-se higienizar a bancada só com 70 em qual com certeza é utilizado com seus trinta por cento de água permite que o ao penetre mais rapidamente no interior do micro das células do microrganismo alterando as camadas de piscas e se naturais proteínas fazemos com que micro-organismos entre o
colapso foi isso nós utilizamos álcool 70 como professora marina disse hoje faremos análise da linguiça colonial para isso faremos primeiro admissão de sinal seriada que apesar 25 gramas e o alimenta e diluir em contato com 225 gramas na água peptonada deram por cento e e aí bom então a gente vai colocar mas tomei que que está programado para um minuto e aí o alimento que eu fiz um fez magadu nossa melissa que o que facilita o contato do diluente o microrganismo essa aqui a diluição 10 da menos um ou seja um caderno mas então ajusta
mais ou menos dois tem colocar 1 ml da solução dessa verdade lição 10 a menos um contudo contém 9 ml de água que tá usando 15 litros de água purificada e essa base transmissão quando for escrever o nome dessa menos dois para fazer lição 10 a menos 3 ou seja um para mil devo pegar um militar da cidade lição 10 a menos 2 pedais 9 ml de água peptonada estamos avistam um para mil 10 a menos 3 nós vamos fazer então certo tem que trabalhar não entre e aí chama entre você e o analito é
porque acho que você contamine o analisa e que o analito porventura contamine você e vamo outubro e coloco um ms e aí e aí eu vou agitar 30 segundos orientador soluções em e depois de 30 segundos espetado no ml e na mostra a direção dessa - 2 e aí a loja do estão me manda uns 3 e aí e aí vamos agitar aí bom então mapa diluição seriada vicinal olá tudo bem agora vou fantásticas motivo consiste e não falar um ml de cada diluição entre pecado no caos lauril sulfato que é o meio para o
teste presuntivo primeira coisa nos identificar rostos lauril sulfato de lição menos um lauril sulfatos de cristão - 11 o lauril sulfato de lição 11 o lauril sulfato de são ano 21 e aí o marilson fácil estão - 21 em vários o fato eles estão nos 21 e ai eu sou fatos estão vendo 31 o mariusz sofá dele está - 31 em vários o fato de ele estar menos três a gente começa a inscrição mais diluída que a júlia está ao menos três e vai até mais concentrada aquele visto ao menos uns nós não precisamos tocar
o fronteira só que eu vou fazer agora a começar com a mesma 31 e aí e aí e onde está um pouquinho no bosque e aí e aí e aí e aí e aí e aí e aí e aí e aí de ficar com mulher vi vocês falando os pelos são - 3 eu coloco o problema é você é e aí e aí e aí e agora hg lição 10 a menos 2 eu não troquei a ponteira e aí e aí e aí e aí e aí e aí e aí bom dia serve sempre foi
um bando o povo ao abrir e não fechar e aí a eliminar as contaminações e e aí e não daqui a um e aí e aí e aí e aí e aí e aí e aí e aí e aí ah tá foi uma colado as divisões e no meu tubo agora eu ajeito um pouco e aí e aí e aí oi tá tudo teste presuntivo já está feita e agora nós devemos cinco barras tudo a 35 graus celsius por 48 horas passadas 48 horas vamos fazer a leitura dos nossos resultados também serve que os três
e a direção mais ou menos um apresentaram resultados positivos apresentaram o que que é resultado positivo essa bolha de ar presidente no tubo de durhan o que significa que o único organismo perguntou à lactose e com produção de gás 13 e aqui na gestão dessa menos dois observe que apenas dois tubos apresentaram o resultado positivo ou seja profissão de garçom avental de tosse com produção de gás é e aí e ainda solicitam mesmo 3 e a pena o youtube apresentou resultado positivo para a presença de coliformes às vezes vamos confirmar que o que tem aqui
nos tudo que apresentaram bolha ou seja produção de gás não realmente coliforme eles vamos fazer primeira coisa vamos identificar custos esse aqui eu caldo bebê que tem um pelos poliformos boa tarde esses dois pontos pegaremos uma estrada do tubo positiva o e colocar ela lá e no e no calor do bebê e se der positivo aqui ou seja temos que limpar o tá isso aqui é o carro descer que é responsável por indicar a presença de coliformes termotolerantes ou seja são os coliformes que per fermenta lactose com produção de gás podem cubase 45 graus celsius
por 48 horas e que horas passa o mau estado estão todos eram positivos para o carro descer esse já preciso de gás após 48 horas e 45 graus celsius significa vezes por formas termotolerantes primeira coisa que a gente faz é enumerar é um todos verde brilhante - 11 o verde brilhante - 11 o verde brilhante - 11 o verde brilhante - 21 e aí eu vejo brilhante - 21 o verde brilhante - 36 - 1 oi e ele te - extra - 2 oi e esse ter ou menos três bem delicadamente deixe ficado nossos tubos
e vamos agora para retirar os microrganismos no caldo ls e passar para as nossas outros meios e hoje nós estamos aqui nós vamos contar com a alça de platina e vamos sambar e eu espero esfriar um pouco e aí o flanco e olha como nós gota e aí e aí e aí e aí e aí e logo novamente e aí e para colocar no caldo de ser um e aí e aí e aí e aí e aí e aí e aí e aí e aí e sempre ficou fazer meia rosca para que permita a entrada
de oxigênio para o crescimento do microrganismo o mesmo para o outro ao teu agora nós vamos fazer a leitura das análises que foram feitas de n p e amostra de instalando ó só relembrando os tubos de lst lauril sulfato triptose com que havia acúmulo de gás foi transferido uma alça deles pro verde brilhante e também para o meio e ser então quê que nós encontramos essa parte é um teste confirmativo e eles foram incubadas numa temperatura de 37° 44 e 45 graus para confirmação dos coliformes termotolerantes estamos de maior relevância visto que imagem noventa porcento
é cole e eles têm uma provável origem fecal hmmmmmmm e como eu comentei anteriormente esse não é uma contagem e sim é um teste de estimativa aproveito para a leitura dos resultados nós temos uma tabela estatística que nós devemos nos basear essa tabela está no material de vocês lá não vou ter então vocês podem acompanhar então esta essa tabela de três tubos série de três tudo isso porque nós utilizamos e como vocês podem observar nela tem 10 100 1000 um que equivale a 10 - 1/10 - 2 e 10 na - 3 e nós temos
que fazer trinca e na diluição menos um nós precisamos contar quantos desses tubos deram positivos os que na teste positivo tinha lugar quais desses conservaram gás no no teste confirmatório estamos para coliformes totais trabalhamos com o verde brilhante tem que observar como vocês podem ver temos uma bolha de gás então primeiro tubo positivo un o segundo tubo também confirmou que se trata de coliforme total ele escreve tudo também tem um nosso primeiro tubo primeiro número para ser procurados na tabela é o três então no 01 que a nossa primeira diluição nós iremos lá no número
três então tem todas essas alternativas de três dependendo da do resto da combinação nós vamos ver o segundo a diluição 02 10 na menos dois o primeiro turbo o negativo o segundo tubo positivo confirmou o terceiro tubo também negativo então nosso segundo o segundo número é um então é 3131 vamos ver a nossa terceira diluição das na menos três primeiro tubo negativo segundo tubo positivo pelo nosso número é 31 e não nossa tabela a 31 equivale a um número 75 tem uns para o número mais provável é 75 colônias de microrganismos programa da amostra analisada
esse é um intervalo de confiança de noventa e cinco porcento e o 31 então no mínimo vai ter 17 microrganismos e no máximo 200 micro-organismos nessa mostra mas o número mais provável é que nesta mostra com tenha 75 coliformes 75 unidades formadoras de colônias de coliformes número 75 número mais provável então são provavelmente colônias bacterianas mas não é uma contagem e foi roubada 37 graus vamos ver para coliformes termotolerantes os antigamente chamados de coliformes fecais tão diluição menos um positivo então temos um positivo o segundo tubo não h negativo o terceiro também negativo tem o
nosso primeiro número é um e aqui na tabela tem 101 que é a 10 - 11 o segundo tubo negativo também e o outro tubo também não curado negativo tem o nosso segundo número é zero porque nenhum deles confirmou a presença de coliformes termotolerantes 110 não temos essa trinca e na divulgação menos três pontinha crescido e no primeiro teste e se não confirmou no presuntivo interessava positivo mas não confirmou ser que pode então gosto número vai ser 100 a 100 3,6 nmp programa então provável no mínimo vai ter 0/17 colônias e no máximo serão 18
colônias bacterianas por grama de amostra visto que a nossa mostra uma amostra sólida não é importante que vocês lembre fixa aqui não é uma contagem como a gente vê em técnicas de plaqueamento mas sim uma estimativa porque leva em consideração tabelas combinatórias estatística e com isso então encerramos a nossa análise de eliane p e alimentos espero que tenha sido claro e qualquer dúvida e pode deixar uma pergunta